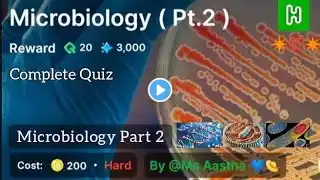
ภาพตัวอย่างวิดีโอ

Microbiology Mcq Questions and Answers | Top 50 MCQs Microbiology | Microbiology GK | Part-I |
Microbiology Mcq Questions and Answers | Top 50 MCQs Microbiology | Microbiology GK | Welcome to your one-stop destination for Microbiology MCQ preparation specially designed for General Knowledge & Government Exams. This platform provides high-yield, exam-oriented multiple-choice questions that are most frequently asked in competitive examinations. 🧫 What You’ll Get Here: ✔️ Most important & repeated Microbiology MCQs ✔️ Short, clear, exam-focused questions ✔️ MCQs for AIIMS, SSC, RRB, ESIC, NHM, State Govt, Paramedical & Nursing exams ✔️ Concepts from Bacteriology, Virology, Mycology, Parasitology, Immunology & Lab Techniques ✔️ Easy-to-remember answers with smart exam tips 🎯 Why This Series is Special: Prepared strictly based on latest exam patterns Focus on high-probability questions Ideal for last-minute revision & quick practice Helpful for students, lab technicians & competitive exam aspirants 🚀 Our Goal: To help you crack government exams confidently by mastering Microbiology through smart MCQ practice. 👉 Stay connected, practice daily, and move one step closer to your government job dream! #microbiolgy #MicrobiologyMCQ #MicrobiologyForGovtExams #GovtExamPreparation #CompetitiveExams #ParamedicalExams #LabTechnicianExam #AIIMSMCQ #SSCExam #RRBExams #NHMExam #MedicalMCQ #BiologyMCQ #MicrobiologyStudy #ExamOrientedMCQ #HighYieldMCQ #GKForGovtExams #MedicalEntrance #NursingExam #HealthcareJobs #SmartStudy